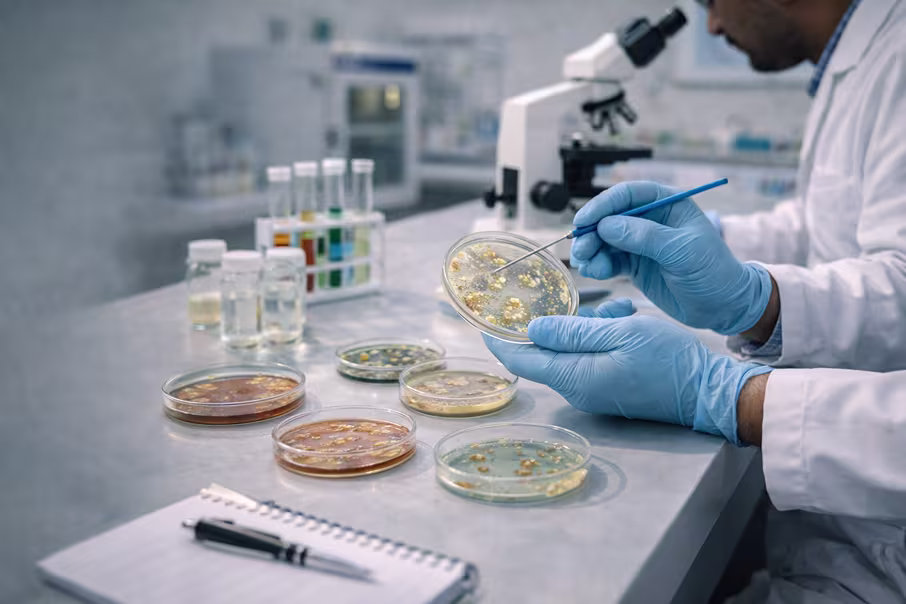
Scientific Illustration

Microbiology Research
Experimental study of microorganisms and their biological activities at SHRIM Bioinnovation & Research.
The Microbiology Research laboratory focuses on studying bacteria, fungi, and their role in biological and environmental systems. Research covers microbial identification, antimicrobial activity testing, and microbial biotechnology applications.
Research Overview
Studying microorganisms and their role in biological, environmental, and industrial systems.
Our laboratory supports experimental microbiology studies that bridge academic training with real scientific outcomes — from identifying microbial species to testing antibiotic susceptibility under controlled conditions.
Research Areas
- Microbial Culturing Techniques
- Bacterial Identification
- Antimicrobial Activity Studies
- Antibiotic Susceptibility Testing
- Microbial Biotechnology Research
Applications
- Pharmaceutical Development
- Environmental Microbiology
- Biotechnology Innovations
- Health & Medical Research
Scope of Microbiology Research
Microbiology is one of the most applied branches of biology — directly contributing to medicine, food science, agriculture, and environmental management. At SHRIM, students and researchers engage with live microbial cultures, work on real experimental protocols, and build skills that are directly transferable to the pharmaceutical, clinical, and biotech industries.
Frequently Asked Questions
Q. What microorganisms are studied at SHRIM?
The laboratory primarily focuses on bacteria and fungi, studying their identification, growth characteristics, and biological activity. Research includes both pathogenic and non-pathogenic microorganisms relevant to pharmaceutical and environmental science.
Q. What is antimicrobial activity testing?
Antimicrobial activity testing involves measuring the ability of a compound — such as a plant extract or chemical agent — to inhibit or kill bacteria and fungi. It is a standard procedure in drug discovery and natural product research.
Q. Can students do an internship in the microbiology lab?
Yes. SHRIM offers dedicated internship and laboratory training programs where students from B.Sc. or M.Sc. backgrounds can work in the microbiology lab and gain practical experience in culturing, staining, and antimicrobial studies.
Q. What is antibiotic susceptibility testing?
Antibiotic susceptibility testing (AST) determines which antibiotics are effective against a specific bacterial strain. It is carried out using disc diffusion or MIC methods — key skills in clinical and pharmaceutical microbiology.
Q. Is microbiology research useful for pharma careers?
Absolutely. Research experience in microbial identification, antimicrobial studies, and antibiotic testing is directly applicable to careers in pharmaceutical companies, food safety labs, clinical diagnostics, and environmental biology.